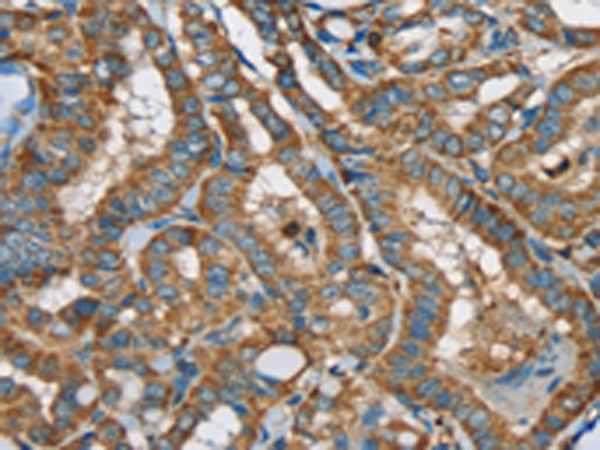

中文名稱: 兔抗SIGLEC7多克隆抗體
英文名稱: Anti-SIGLEC7 rabbit polyclonal antibody
儲 存: 冷凍(-20℃)
宿 主: Rabbit
抗 原: SIGLEC7
反應(yīng)種屬: Human
標(biāo) 記 物: Unconjugate
克隆類型: rabbit polyclonal
技術(shù)規(guī)格
|
Background: |
Siglec-7, which is highly expressed in monocytes and resident blood cells but not in parenchymatous cells, mediates inhibition of natural killer cell cytotoxicity. Due to alternative splicing events, two isoforms exist for Siglec-12, namely SLG-L (the long isoform) and SLG-S (the shorter isoform). These isoforms are differentially expressed with the longer isoform predominantly found in small intestine, spleen and bone marrow, and the shorter isoform predominantly found in small intestine, spleen and adrenal gland. |
|
Applications: |
ELISA, IHC |
|
Name of antibody: |
SIGLEC7 |
|
Immunogen: |
Synthetic peptide of human SIGLEC7 |
|
Full name: |
sialic acid binding Ig-like lectin 7 |
|
Synonyms: |
p75; QA79; AIRM1; CD328; CDw328; D-siglec; SIGLEC-7; SIGLECP2; SIGLEC19P; p75/AIRM1 |
|
SwissProt: |
Q9Y286 |
|
ELISA Recommended dilution: |
1000-2000 |
|
IHC positive control: |
Human thyroid cancer and Human brain |
|
IHC Recommend dilution: |
25-100 |
購物車
購物車 幫助
幫助
 021-54845833/15800441009
021-54845833/15800441009
